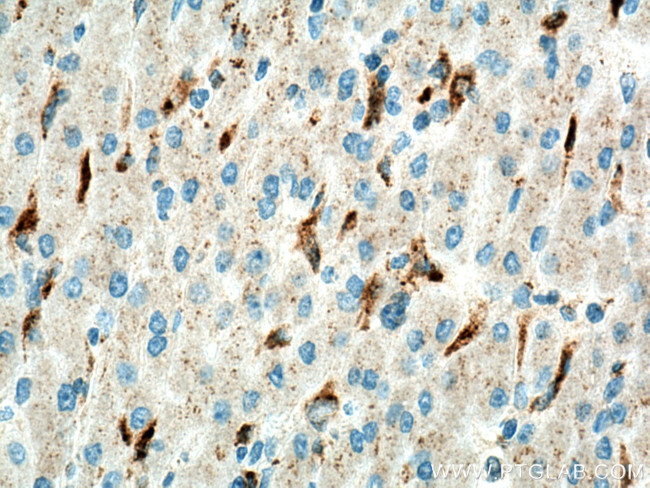
LYPLA3 Antibody in Immunohistochemistry (Paraffin) (IHC (P))

Search
Proteintech
LYPLA3 Polyclonal Antibody
{{$productOrderCtrl.translations['antibody.pdp.commerceCard.promotion.promotions']}}
{{$productOrderCtrl.translations['antibody.pdp.commerceCard.promotion.viewpromo']}}
{{$productOrderCtrl.translations['antibody.pdp.commerceCard.promotion.promocode']}}: {{promo.promoCode}} {{promo.promoTitle}} {{promo.promoDescription}}. {{$productOrderCtrl.translations['antibody.pdp.commerceCard.promotion.learnmore']}}
产品信息
10863-2-AP
种属反应
宿主/亚型
分类
类型
抗原
偶联物
形式
浓度
规格
纯化类型
保存液
内含物
保存条件
运输条件
产品详细信息
Immunogen sequence: SYFHTMVES LVGWGYTRGE DVRGAPYDWR RAPNENGPYF LALREMIEEM YQLYGGPVVL VAHSMGNMYT LYFLQRQPQA WKDKYIRAFV SLGAPWGGVA KTLRVLASGD NNRIPVIGPL KIREQQRSAV STSWLLPYNY TWSPEKVFVQ TPTINYTLRD YRKFFQDIGF EDGWLMRQDT EGLVEATMPP GVQLHCLYGT GVPTPDSFYY ESFPDRDPKI CFGDGDGTVN LKSALQCQAW QSRQEHQVLL QELPGSEHIE MLANATTLAY LKRVLLGP (1-277 aa encoded by BC011640)
靶标信息
Lysophospholipases are enzymes that act on biological membranes to regulate the multifunctional lysophospholipids. The protein encoded by this gene hydrolyzes lysophosphatidylcholine to glycerophosphorylcholine and a free fatty acid. This enzyme is present in the plasma and thought to be associated with high-density lipoprotein. A later paper contradicts the function of this gene. It demonstrates that this gene encodes a lysosomal enzyme instead of a lysophospholipase and has both calcium-independent phospholipase A2 and transacylase activities.
仅用于科研。不用于诊断过程。未经明确授权不得转售。
篇参考文献 (0)
生物信息学
蛋白别名: 1-O-acylceramide synthase; 1-O-acylceramide synthase {ECO:0000303|PubMed:15294901}; ACS; ACS {ECO:0000303|PubMed:15294901}; BMP hydrolase; group XV phospholipase A2; group XV phospholipase A2 {ECO:0000312|EMBL:AAH98894.1}; LCAT-like lysophospholipase; LCAT-like lysophospholipase {ECO:0000250|UniProtKB:Q8VEB4}; LLPL; LLPL {ECO:0000250|UniProtKB:Q8VEB4}; LPLA2; LPLA2 {ECO:0000303|PubMed:15294901}; Lysophospholipase 3; lysophospholipase 3 (lysosomal phospholipase A2); lysophospholipase 3 {ECO:0000250|UniProtKB:Q8VEB4}; Lysosomal phospholipase A and acyltransferase; Lysosomal phospholipase A2; lysosomal phospholipase A2 {ECO:0000303|PubMed:15294901, ECO:0000312|EMBL:AAS66767.1}; Phospholipase A2 group XV; PLA2G15; pla2g15 {ECO:0000312|Ensembl:ENSRNOP00000026996, ECO:0000312|RGD:1302982}; unnamed protein product
基因别名: 1-O-acylceramidesynthase; ACS; C87498; GXVPLA2; LLPL; LPLA2; LYPLA3; PLA2G15; UNQ341/PRO540
UniProt ID: (Human) Q8NCC3, (Mouse) Q8VEB4, (Rat) Q675A5
Entrez Gene ID: (Human) 23659, (Mouse) 192654, (Rat) 361401